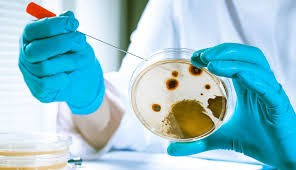

Overview and Importance
The Good Laboratory Practices program (GMP for laboratories, or GLP sometimes in quality assurance contexts) is a systematic framework that ensures all analytical and experimental activities in the lab are conducted in a uniform, reliable, and repeatable manner. The program aims to maintain the highest standards of quality and integrity for the produced data, whether it is chemical or microbiological data.
This program is the cornerstone in many industries, especially:
- Pharmaceutical and cosmetic industries
- Food and beverage industry
- Water and environment sector
- Scientific research and development
Key Components and Pillars of the Program
The program is based on several fundamental principles including:
1. Sample management and control
2. Equipment and instrument management
3. Materials and media
4. Standard Operating Procedures (SOPs)
5. Data management and documentation
6. Competence and training
7. Quality assurance and internal review
8. Laboratory safety
Difference in Application for Microbiological and Chemical Testing
- In the chemical laboratory: The program focuses on measurement accuracy, reagent purity, and calibration of precise analytical instruments.
- In the microbiological laboratory: The program focuses on contamination prevention, verifying the effectiveness of media and sterilization methods, and ensuring suitable growth conditions for microorganisms (temperature, humidity, gases).
Conclusion: The Good Laboratory Practices program for laboratories is not just a set of rules, but a quality culture applied daily to ensure that every report issued by the laboratory accurately and confidently reflects test results, supporting sound decision-making in public health, safety, and quality fields.